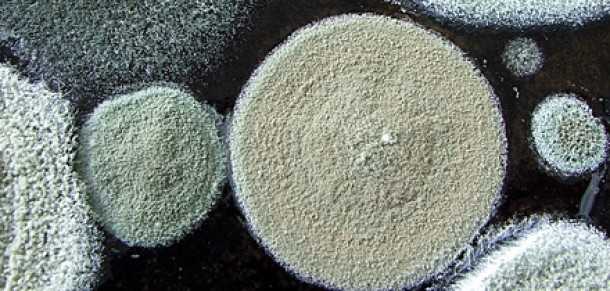

Mucegaiul – o problema globala
Pe toata suprafata pamantului exista peste 100.000 de specii de mucegai. Sa nu fii surprinsa daca mucegaiul poate fi gasit prin cele mai nebanuite locuri. De origine animala sau vegetala, mucegaiurile sunt organisme microscopice care produc enzime ce distrug materia organica si se reproduc prin spori. Aceste microorganisme fac parte din regnul fungilor, inrudindu-se cu ciupercile, drojdia de bere si rugina. Mucegaiul joaca un rol extrem de important in natura, mai ales in descompunerea frunzelor, a lemnului sau a altor resturi vegetale.
Unde apare mucegaiul?
Mucegaiul se dezvolta in conditii de umezeala si caldura, dar il poti gasi in orice perioada a anului in diverse medii, atat interioare cat si exterioare. Daca iti plac plimbarile in natura, risti sa-l intalnesti in special in locurile umbroase si umede. Gasesti mucegai chiar si la tine acasa: in subsol, in baie, bucatarie sau pe alte suprafete cu un nivel ridicat de umezeala. Igrasie sau mucegai, oricum i-ai spune, vorbim de acelasi lucru: probleme majore care cer solutii imediate.
Invazie de spori: ia atitudine!
O data ce sporii de mucegai s-au instalat in casa ta, orice urma de umiditate ii va ajuta sa se dezvolte. Trebuie sa acorzi o mare atentie lemnului, tavanului, tapetului, covoarelor si podelelor si sa verifici daca sunt mucegaite. Este esential sa nu uiti de colturile mai izolate din locuinta ta. Cu siguranta nu vrei sa ai un chirias nepoftit in casa. Daca umiditatea persista, atunci va aparea si mucegaiul. Dar daca vrei sa iei masuri, va trebui mai intai sa controlezi umiditatea.
Este mucegaiul periculos pentru sanatate? Depinde. Nu incerca sa-l indepartezi prin razuire, sporii vor zbura liberi prin aerul pe care il respiri. De asemenea, poti fi expusa la boli respiratorii daca intri in contact direct cu suprafete contaminate. Persoanele bolnave sau cu imunitate scazuta sunt cele mai afectate.
Identifica spatiile contaminate
Este posibil sa fi vazut din loc in loc particule albicioase sau pete negre de umezeala in baie. Sau poate ai simtit mirosul de mucegai. Aceste semne indica faptul ca ai probleme cu igrasia. Fii atenta la zonele in care exista infiltratii de apa din cauza inundatiilor sau a instalatiilor deteriorate. Mucegaiul poate fi gasit si in spatiile fara umiditate. Ai grija la haine!
Cum trebuie sa actionezi
Nu este cazul sa te sperii, poti controla dezvoltarea mucegaiului in casa. In primul rand, opreste scurgerile de apa, apoi ventileaza-ti casa si curata obiectele din material textil. Pe cele irecuperabile inlocuieste-le cu altele noi. Daca este vorba de o suprafata mica si daca nu esti alergica la mucegai, atunci poti sa te apuci singura de curatat. Pentru suprafetele mai intinse apeleaza la o firma specializata. Foloste o masca sau ochelari de protectie si manusi! Va trebui sa pastrezi un nivel de umiditate potrivit si sa-ti aerisesti bine locuinta. Riscul de contaminare cu mucegai poate fi diminuat daca urmezi aceste recomandari. E greu, dar merita!

Castiga cu cea mai urata piesa de mobilier
Castiga cu cea mai urata piesa de mobilier
 Cum sa-ti pregatesti casa pentru primavara
Cum sa-ti pregatesti casa pentru primavara
















































